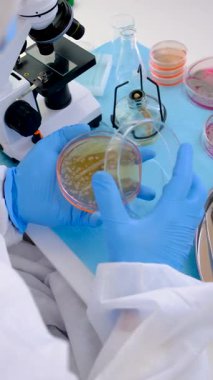
Laboratuvardaki petri kabındaki bakterileri inceleyin. Seçici odaklanma. Doğa.
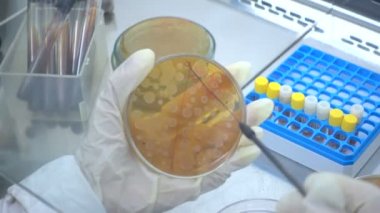
Mikrobiyolojik laboratuvar çalışma. Laboratuvarda deneme. Örnek seçimi. Bakterilerin bir petri üzerinde büyük bir yük bitki. Labortory, gerçek eser.
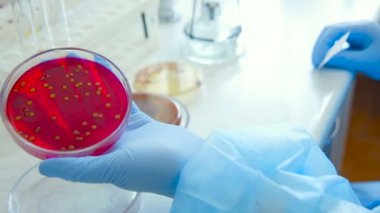
Koloni mikroplar ve bakteriyolojik bir laboratuvar Petri kabına patojenik mantar

İhlal Bildirim Formu
En Çok Aranan Kelimeler
donanımbüyümeSağlıkTabakİlaç.Sağlık hizmetleriTıbbiteknolojiEl.DoktorHastaneTest etHastalıkkültürörnekbiyolojiDeneyLaboratuvarBilimGüvenliKeşifanalizvirüsBakteriaraştırmaeldivenBilimselinceleyinmikroorganizmaKirlenmeİncelemebiyokimyaBiyoteknoloji.bilim adamıBakterilerMikroskopMikrobiyolojimikroplarkolonilerPetripastörbakteriyolojininmikrobiyalBoşluğu kopyalaPetri Çanağı4 kBenzer İçerikler